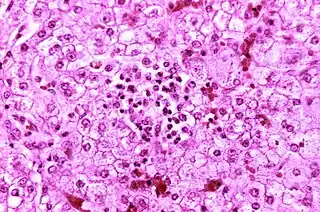

| Síndrome de Reye | ||
|---|---|---|
![]() Histopatología de un hígado autópsico procedente de un niño que murió de síndrome de Reye. Los hepatocitos se tiñen pálidamente debido a las gotitas intracelulares de grasa. | ||
| Especialidad | neurología | |
| Sinónimos | ||
| Hígado graso con encefalopatía. | ||
El síndrome de Reye es una enfermedad pediátrica grave que suele producirse con mayor frecuencia en niños menores de 10 años. Se caracteriza por encefalopatía no específica de progresión rápida,[1] con degeneración adiposa de las vísceras y alteración del metabolismo. Afecta principalmente al hígado y cerebro.
Es una esteatosis hepática microvesicular. El sistema nervioso central aparece edematoso.
Al microscopio electrónico se ven unas mitocondrias anormales. La causa de la enfermedad es un trastorno mitocondrial sistémico que impide la β-oxidación de los ácidos grasos.
Epidemiología
La primera descripción detallada del síndrome de Reye fue realizada en 1963 por Douglas Reye.[2]
Es una afección de etiología desconocida,[1] ha sido considerada como una enfermedad rara, con una incidencia situada alrededor de 0,1-0,5/100 000 niños por año,[1] con variaciones según los países la tasa puede llegar hasta 6/ 100 000. Se cree que es una enfermedad mitocondrial, precipitada por un virus,[3] en especial los de la influenza o la varicela.[3] Suele aparecer en niños de entre 4 a 16 años de edad aunque el grupo más expuesto se encuentra entre los 6-10 años, sin preferencia de sexo.
La American Academy of Pediatrics no recomienda el consumo de aspirina y otros antiinflamatorios no esteroideos en procesos febriles virales, porque al parecer el consumo del fármaco se relaciona con el síndrome.[1]
El primer estudio de casos y controles que demostró una asociación entre el síndrome Reye y los salicilatos en niños con enfermedad vírica previa, apareció en 1980. Esta se siguió de tres estudios adicionales de casos y controles publicados en 1982. En todos estos estudios se encontró una fuerte asociación y más del 95 % de los casos habían estado expuestos a los salicilatos. Cuanto menor sea el niño, más altas serán las tasas de morbidez y mortalidad.
Sintomatología
El cuadro clínico es característico en el proceso de recuperación de una infección viral.[4]
Se trata de una encefalopatía de comienzo abrupto asociado a daño hepático. Comienza con malestar general, vómitos persistentes, seguido de cambios en el comportamiento, habitualmente referido como comportamiento agresivo, letargo, pérdida de consciencia.[3] En ocasiones se observa acidosis metabólica y alcalosis respiratoria. Puede haber cambios en el nivel de conciencia del paciente, convulsiones, coma y muerte. Es un cuadro con una mortalidad elevada, entre el 20 al 40%, aunque con buen pronóstico para los pacientes que superan el cuadro agudo.
La progresión del síndrome se puede seguir en cinco etapas:[5][6][7]
- Etapa I
- Etapa II
- Estupor
- Hiperventilación
- Esteatosis hepática (encontrada por biopsia)
- Hiperreflexia
- Etapa III
- Continuación de los síntomas de las etapas I y II
- Posible coma
- Posible edema cerebral
- Raramente, paro respiratorio
- Etapa IV
- Profundización del coma
- Dilatación de las pupilas, con mínima respuesta a la luz
- Mínima, pero presente disfunción hepática
- Etapa V
- Comienzo muy rápido después de la etapa IV
- Coma profundo
- Convulsiones
- Síndrome de disfunción multiorgánica[9]
- Parálisis flácida
- Hiperamonemia (por encima de 300 mg/dL de sangre)
- Muerte
Diagnóstico
El diagnóstico se basa en antecedentes del paciente, síntomas y datos clínicos. En el examen físico, se destacan: somnolencia, vómitos, evidencias de laboratorio de disfunción hepática, letargo, cambios del comportamiento y del nivel de conciencia, hiperventilación, diplopía, pérdida de sensibilidad de miembros, convulsiones, postura de descerebración, hepatomegalia.
Además de la sintomatología anteriormente citada, hay ciertos marcadores plasmáticos de utilidad: hipoglucemia, elevación de las enzimas hepáticas, aumento del amonio plasmático. En cuanto a los estudios complementarios: química sanguínea, tomografía, electroencefalograma, resonancia magnética (se observa edema cerebral entre otros cambios).
Diagnóstico diferencial
Algunas de las distintas afecciones que pueden causar síntomas similares son las siguientes.
- Hemorragia intracraneana
- Encefalitis viral
- Sobredosis de una droga o envenenamiento
- Traumatismo craneal
- Meningitis
- Insuficiencia hepática debida a aumento de amonio
- Insuficiencia renal
- Varicela
Tratamiento
Se realiza tratamiento de sostén,[3] con mantenimiento de las funciones vitales, resguardo de la función respiratoria y corrección de parámetros sanguíneos; con prioridad particular a la prevención de lesiones cerebrales, pues el proceso patológico es reversible en gran parte de los demás órganos. Es crucial el manejo de los líquidos aunado al tratamiento, debido al aumento de presión intracraneal. Puede requerir apoyo mecánico para la función respiratoria. No tiene un tratamiento específico.
Hace muchos años, cuando el cuadro era mucho más frecuente, se realizaba una depuración sanguínea con carbón activado. Ahora se suelen utilizar fármacos que ayudan en el resto de las encefalopatías que incluye diuréticos osmóticos, sedantes y barbitúricos, junto con esquema de antibióticos para infecciones secundarias.
Secuelas
El paciente que supere el cuadro agudo puede quedar libre de secuelas o presentar daño de alguna función del sistema nervioso central.
Prevención
Se debe evitar el uso de los antiinflamatorios no esteroideos del grupo de los salicilatos en niños menores de 10 años en los procesos febriles de origen viral, como la gripe por ejemplo. También debe evitarse su uso después de recibir la vacuna de la varicela, ya que existe el riesgo de desarrollar el síndrome. También el uso de aspirina mientras se padece varicela está asociado al síndrome de Reye en niños. Debe tenerse en cuenta que hay muchos preparados farmacéuticos en el mercado que poseen en su formulación salicilatos, por lo cual deben evitarse también en la infancia.
Debe prevenirse el consumo indiscriminado de este grupo de AINEs dado lo arriesgado de su administración en niños. En adultos, los salicilatos, también producen efectos adversos en el sistema gastrointestinal y renal, por lo cual tampoco son inocuos para este rango etario.
Ante cualquier duda, debe consultarse a un profesional de la salud.
- Uso de aspirina
Su principio activo es extraído del tallo del sauce, y ha sido utilizado desde el siglo V. En 1853 fue sintetizada como ácido acetilsalicílico por primera vez, por el químico francés Charles Frédéric Gerhardt.
En su forma comercial, no se debe administrar en niños menores de 12 años que padezcan gripe o varicela (por lo general se usa paracetamol en vez) y/o usar en conjunto con otros salicilatos, por los riesgos asociados con el Síndrome de Reye. La administración de aspirina durante un cuadro de dengue no se recomienda por el aumento del riesgo de hemorragias.
- Sustitutos de aspirina
La más común es la acetaminofén (paracetamol) (Tylenol, Anacin-3), que reduce la fiebre y alivia el dolor de manera muy semejante a la aspirina, aunque no aminora la inflamación. El uso excesivo de acetaminofén puede ocasionar daño renal y hepático. Un segundo sustituto común es el Ibuprofeno (Advil, Nuprin y Motrin IB), que funciona justo como la aspirina para reducir dolor, fiebre e inflamación. Otra adición a la familia de los sucedáneos de la aspirina que se venden sin receta es el naproxeno (Aleve). Su principal ventaja es su efecto duradero. Mientras que casi todos los analgésicos requieren dosis cada 4-6 horas, una sola tableta de naproxeno dura 8-12 horas
Referencias
- 1 2 3 4 Pugliese, A; Beltramo, T; Torre, D (octubre de 2008). «Reye's and Reye's-like syndromes.». Cell biochemistry and function 26 (7): 741-6. PMID 18711704. doi:10.1002/cbf.1465.
- ↑ McMillan, Julia A.; Feigin, Ralph D.; DeAngelis, Catherine; Jones, M. Douglas (2006). Oski's Pediatrics: Principles & Practice (en inglés). Philadelphia: Lippincott Williams & Wilkins. p. 2306. ISBN 9780781738941.
- 1 2 3 4 «NINDS Reye's Syndrome Information Page». NINDS. 25 de septiembre de 2009. Archivado desde el original el 1 de agosto de 2016. Consultado el 8 de agosto de 2016.
- ↑ Schulte, Elizabeth B; Price, Debra L; Thompson, Eleanor Dumont (1999). Enfermería pediátrica de Thompson. Traductores: Guillermina Cuevas Meza, Guillermina Féher de la Torre (Séptima edición). México D. F.: McGraw-Hill Interamericana. ISBN 9701038185.
- ↑ Knight, J. (2009). «Reye's Syndrome». Healthy Child Care 12 (4). Archivado desde el original el 22 de mayo de 2013.
- ↑ Boldt, D.W. (febrero de 2003). «Reye Syndrome». University of Hawaii John A. Burns School of Medicine.
- ↑ «What is Reye's Syndrome?». National Reye's Syndrome Foundation. Archivado desde el original el 11 de mayo de 2013. Consultado el 20 de junio de 2017.
- ↑ «Reye's Syndrome». KidsHealth.org. Nemour Foundation. Consultado el 6 de febrero de 2015.
- ↑ Ku AS; Chan LT (abril de 1999). «The first case of H5N1 avian influenza infection in a human with complications of adult respiratory distress syndrome and Reye's syndrome». Journal of Paediatrics and Child Health 35 (2): 207-9. PMID 10365363. doi:10.1046/j.1440-1754.1999.t01-1-00329.x.
Enlaces externos
- Síndrome de Reye MedlinePlus
- http://www.med.nyu.edu/content?ChunkIID=103512
- https://web.archive.org/web/20150717010506/http://www.ops.org.bo/textocompleto/rnsbp87260306.pdf (hace referencia a la clasificación de Lovejoy)
- http://www.aepd.es/sites/default/files/documentos/II-reye.pd (enlace roto disponible en Internet Archive; véase el historial, la primera versión y la última).
- http://www.health.harvard.edu/fhg/updates/overdoing-acetaminophen.shtml (Inglés, hace referencia a la relación entre el acetaminofén y el Síndrome de Reye)